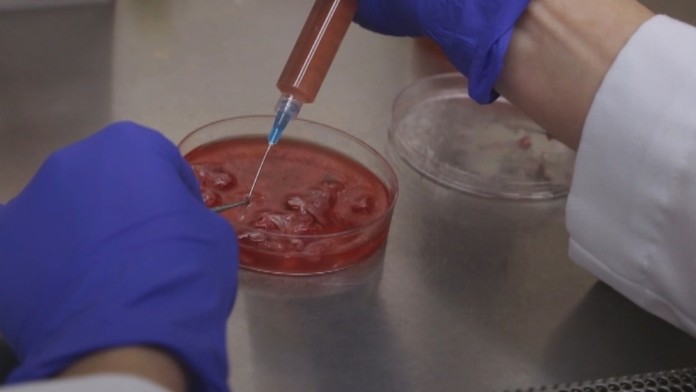
19_rakovinaweb_jpg_bez_watermarku_1.jpg

Chemoterapia už nebude potrebná. Je tu účinný liek na rakovinu!
Experimentovanie s týmto systémom už zabralo u pacientov s rôznymi druhmi rakoviny.
Britka Pam bojovala s rakovinou kože, ktorá sa jej postupne rozšírila aj do iných častí tela. Za pol roka sa jej melanóm zmenšil z deviatich na štyri milimetre a ďalší nález na pľúcach postupne mizne. Američanka Clara mala zas nádor na mozgu. V roku 2012 jej dávali lekári šesť mesiacov života. Má dve malé deti a dnes už myslí pozitívne.
Tím expertov prišiel totiž na to, že nádor dokáže naše telo zneškodniť samo, musí mať ale silný imunitný systém. Vybraným pacientom podávali niekoľko mesiacov lieky na podporu imunity a väčšine z nich už rakovina ustupuje. A to úplne bez chemoterapie. Nová sľubná liečba dostala pracovný názov "imunoterapia". Lekári, ktorí ju vymysleli, na ňu nedajú dopustiť a nie sú jediní. Experimentovanie s imunitným systémom zabralo u pacientov s rôznymi druhmi rakoviny.Z tisícky onkologických pacientov, ktorých liečili imunoterapiou, má sľubné výsledky až 58 percent.
Zatiaľ čo u Pam imunoterapia očividne zabrala, Clara na dobré správy zatiaľ len čaká. Jej nádor sa nezmenšil. Ale ani nenarástol. Obidve ženy zariskovali, keď ochotne prijali experimentálnu liečbu a vzdali sa chemoterapie. Podľa lekárov to neoľutujú.
"Imunitný systém sme u pacientok naštartovali natoľko, že dokáže vystopovať nádor, nech je kdekoľvek. Jeho bunky potom pomaly imunita zabíja jednu pod druhej a to bez toho, aby poškodila zdravé bunky okolo v okolí nádoru," hovorí expert na imunoterapiu John Sampson
Za všetkým je kombinácia dvoch liekov, ktoré prebudia obranyschopnosť organizmu a povzbudia ju tak, aby fungovala na plné obrátky. Z tisícky onkologických pacientov, ktorých liečili imunoterapiou, má sľubné výsledky až 58 percent. Problémom je nateraz cena liečby. Tá sa môže vyšplhať na niekoľko desiatok tisíc eur.
Sledujte Televízne noviny vo full HD a bez reklám na Voyo
































